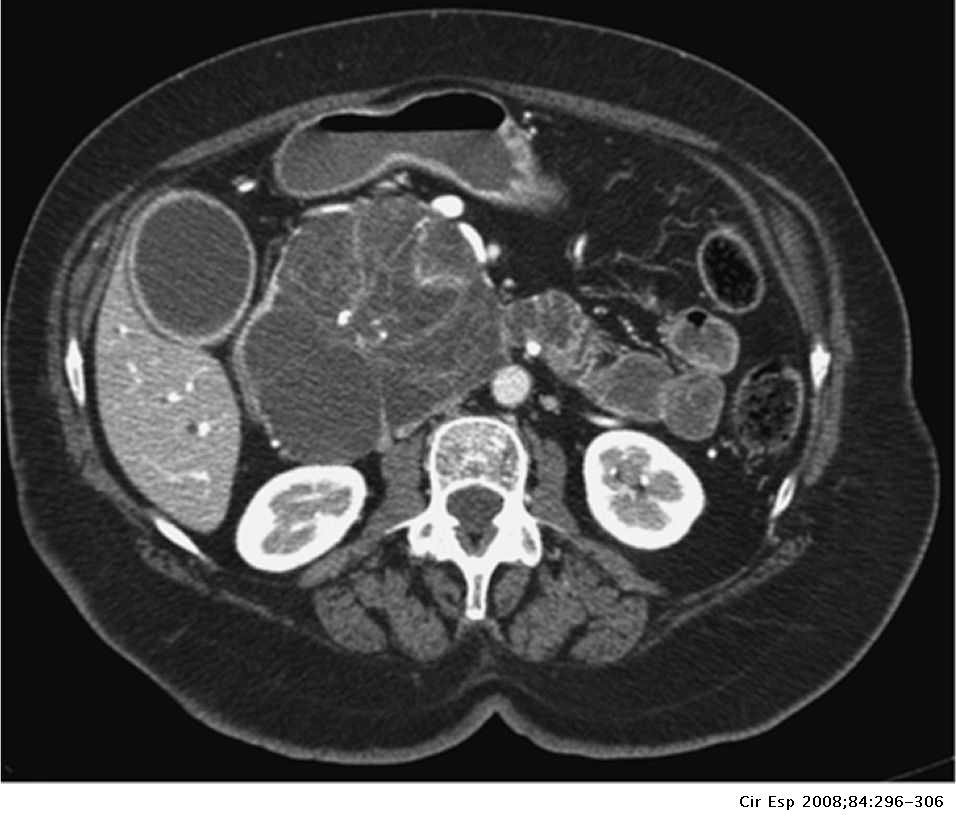
Neoplasias quísticas del páncreas. Manejo diagnóstico y terapéutico

El cistoadenoma seroso del páncreas es un tumor benigno de este órgano. Generalmente se encuentra en la cola del páncreas,[1] y puede estar asociado con el síndrome de von Hippel-Lindau.[2]
En contraste con algunos de los otros tumores del páncreas que forman quistes (como la neoplasia mucinosa papilar intraductal y la neoplasia quística mucinosa), las neoplasias quísticas serosas son casi siempre completamente benignas. Hay algunas excepciones; en raras ocasiones, se han descrito casos de cistoadenocarcinomas serosos malignos aislados.[3] Además, las neoplasias quísticas serosas crecen lentamente y, si crecen lo suficiente, pueden presionar los órganos adyacentes y causar síntomas.
Clasificación
Los patólogos clasifican las neoplasias quísticas serosas en dos grandes grupos. Aquellas que son benignas, que no se han diseminado a otros órganos, se denominan "cistoadenomas serosos".[4] Los cistoadenomas serosos pueden subdividirse en microquístico, oligocístico (o macrocístico), sólido, neoplasia endocrina mixta y neoplasia serosa asociada a VHL. Este último esquema de clasificación es útil porque destaca la variedad de aspectos y las asociaciones clínicas de estas neoplasias. Las neoplasias quísticas serosas que se han diseminado ("metastatizado") a otro órgano se consideran malignas y se denominan "cistoadenocarcinoma seroso".
Patología
Tratamiento
Estas lesiones rara vez requieren cirugía excepto si son sintomáticas o el diagnóstico está en duda. Dado que no tienen potencial maligno, la observación a largo plazo es innecesaria. La cirugía puede incluir la extirpación de la cabeza del páncreas (una duodenopancreatectomía), la extirpación del cuerpo y la cola del páncreas (una pancreatectomía distal) o, rara vez, la extirpación de todo el páncreas (una pancreatectomía total).[5] En algunos casos, la cirugía se puede realizar utilizando técnicas mínimamente invasivas, como la laparoscopia.[6]
Véase también
- Cistoadenoma seroso ovárico
- Tumor pseudopapilar sólido
Referencias
Enlaces externos